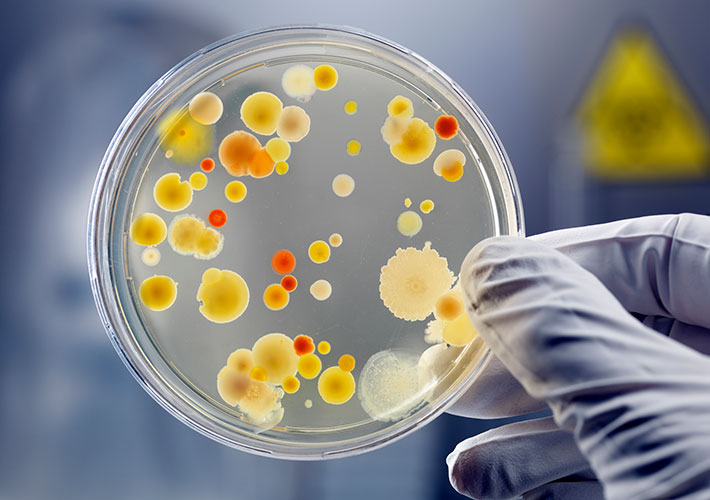
News image

May 16, 2018
A new ASTM International standard will allow users to grow a standardized bacterial biofilm that can be used in the efficacy evaluation of antimicrobial disinfectants. The new standard (soon to be published as E3161) was developed by the ASTM International committee on pesticides, antimicrobials, and alternative control agents (E35).
According to committee members, bacteria may grow and persist as free floating cells in liquids or attached to surfaces as biofilms. In the latter case, the biofilm provides embedded bacteria with protection from dehydration and other environmental stresses and may interfere with the action of chemical disinfectants.
Bacteria in biofilms have the capacity to survive environmental stress and may serve as a reservoir of human pathogenic bacteria. This standard specifies the parameters for growing a Pseudomonas aeruginosa or Staphylococcus aureus biofilm that can be used to evaluate the efficacy of antimicrobial disinfectants.
To purchase standards, contact ASTM International customer relations (tel +1.877.909.ASTM; ).
July / August 2018
028